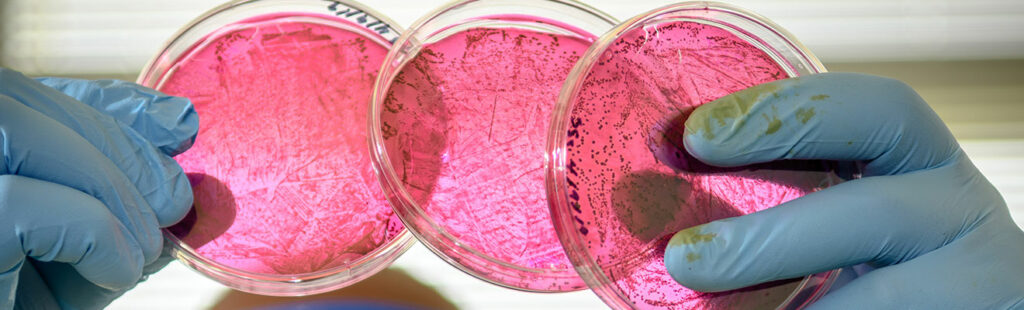
A male student in lab environment is examining some brightly colored petri dishes. He is wearing protective goggles and gloves.

Retail Studies, M.S.
If you have an interest in fashion, the Bryan School’s Department of Consumer, Apparel, and Retail Studies (CARS) offers the best preparation for becoming what we see in you: a work-ready professional with all of the experience, knowledge, and networking you need to build a successful career. Our graduate program… Continue reading…